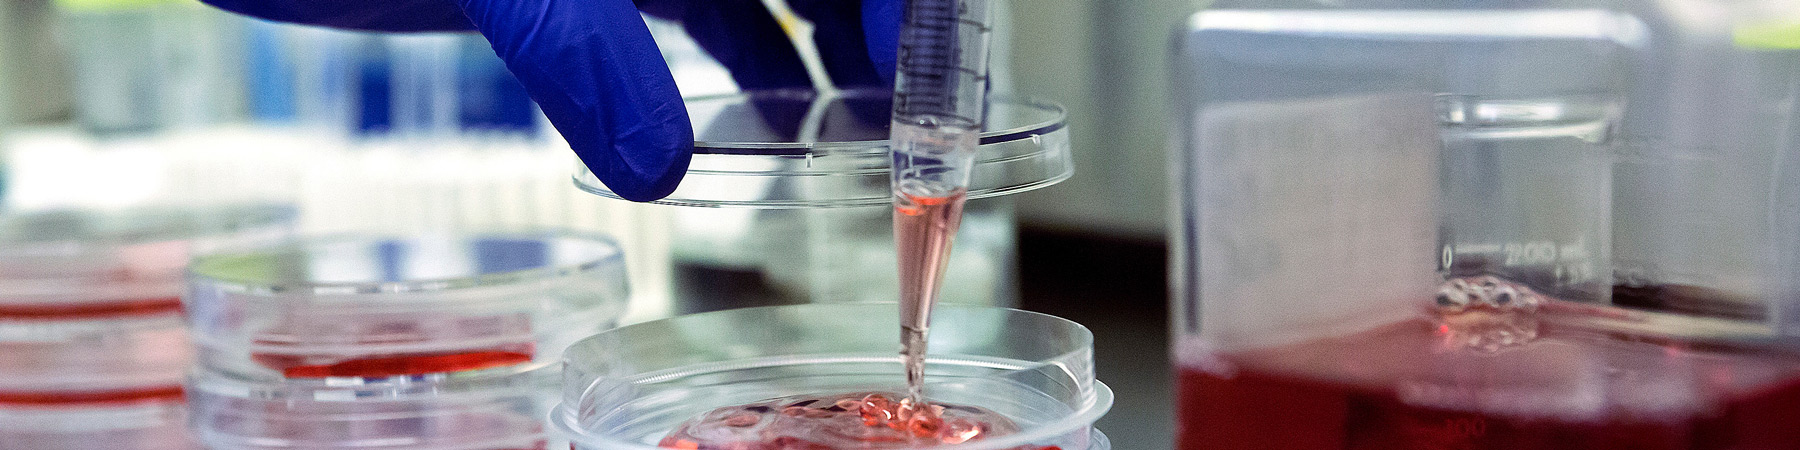
Medical lab

Alumni
Once a Rambler, always a Rambler.
As a Parkinson alum, you are an integral part of our community. You help shape our curriculum, engage in inter-professional dialogue, and inspire the next generation of public health and health care leaders. We also want to help you stay connected with the Loyola community and flourish in your career. Continue your journey of being a transformative agent for change and good.
LoyolaLinked
Through the Parkinson community on LoyolaLinked, Parkinson alumni can find professional connections and advice, as well as provide undergraduate and graduate students with critical insights about the public health and health care industries.
Alumni Career Resources
Parkinson alumni have access to all of the career resources available through Loyola’s Office of Alumni Relations. Also be sure to check out their events calendar. For additional information or questions, please contact at 773.508.3730 or LUC-ALUM@LUC.edu.
Once a Rambler, always a Rambler.
As a Parkinson alum, you are an integral part of our community. You help shape our curriculum, engage in inter-professional dialogue, and inspire the next generation of public health and health care leaders. We also want to help you stay connected with the Loyola community and flourish in your career. Continue your journey of being a transformative agent for change and good.
LoyolaLinked
Through the Parkinson community on LoyolaLinked, Parkinson alumni can find professional connections and advice, as well as provide undergraduate and graduate students with critical insights about the public health and health care industries.
Alumni Career Resources
Parkinson alumni have access to all of the career resources available through Loyola’s Office of Alumni Relations. Also be sure to check out their events calendar. For additional information or questions, please contact at 773.508.3730 or LUC-ALUM@LUC.edu.
